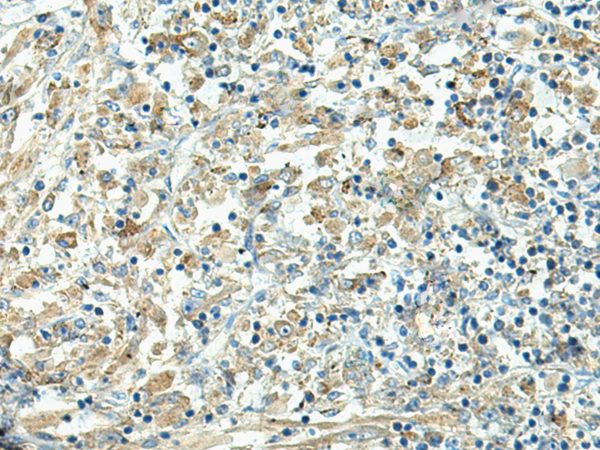

Background:
This gene encodes a receptor that binds the Fc region of monomeric immunoglobulin G. The encoded protein transfers immunoglobulin G antibodies from mother to fetus across the placenta. This protein also binds immunoglobulin G to protect the antibody from degradation. Alternative splicing results in multiple transcript variants.
Applications:
ELISA, WB, IHC
Name of antibody:
FCGRT
Immunogen:
Synthetic peptide of human FCGRT
Full name:
Fc fragment of IgG receptor and transporter
Synonyms:
FCRN; alpha-chain
SwissProt:
P55899
ELISA Recommended dilution:
5000-10000
IHC positive control:
Human liver cancer and Human thyroid cancer
IHC Recommend dilution:
30-150
WB Predicted band size:
40 kDa
WB Positive control:
Human placenta tissue lysate
WB Recommended dilution:
500-2000

購(gòu)物車
幫助
021-54845833/15800441009
